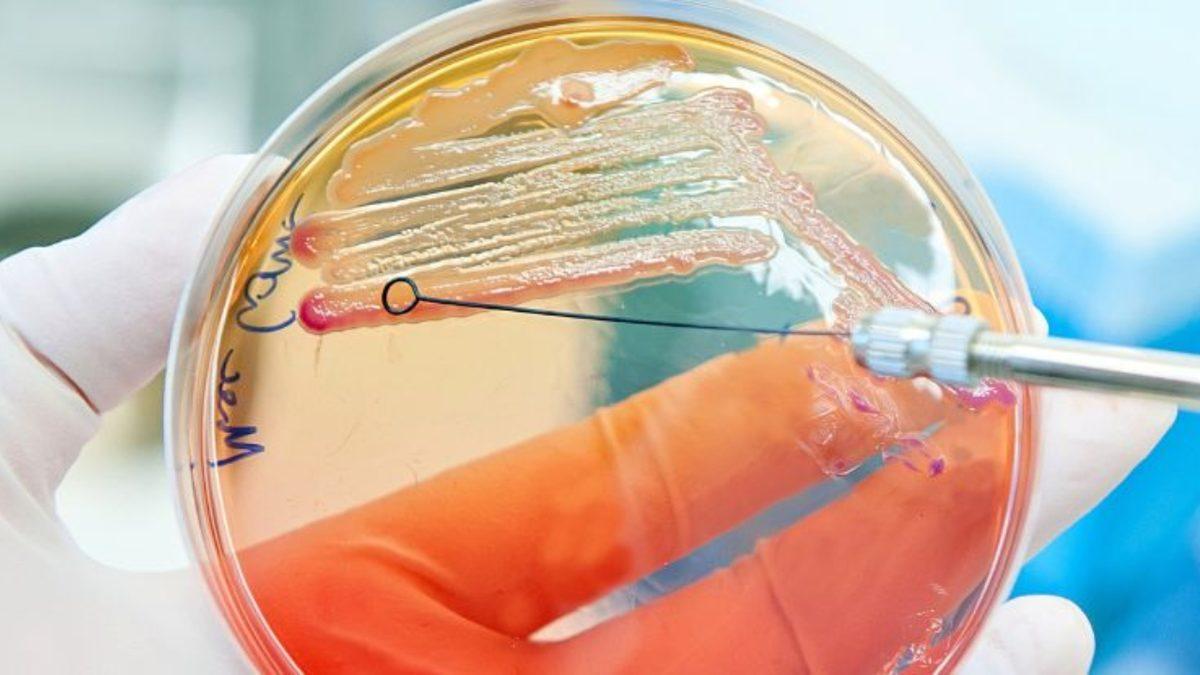
Faydalı Bakterilere Zarar Vermeyen Bir Antibiyotik Keşfedildi

Bugüne kadar kullanılan antibiyotiklerin genel sorunu, bir defa vücudumuza girdikten sonra bakterileri iyi-kötü diye ayırmaksızın yok etmesidir. Bu yüzden de antibiyotikler ile birlikte genelde bağırsak faunasını koruyabilecek ek ilaçlar ile birlikte de kullanılırlar. Yine de bu önlemler her zaman yeterli olamayabiliyor.
Zaman zaman antibiyotiklerin bu etkisi bakterilerin yarattığı zararların bile önüne geçebiliyor. Örneğin kadınlarda antibiyotik kullanımından sonra enfeksiyonlara daha açık oluyorlar. Illinois Üniversitesinden araştırmacıların geliştirdiği Iolamicin adlı antibiyotik ise bu sorunu çözmeyi vaat ediyor.
Dirençli bakterilere karşı yeni umut
Gram-negatif bakteri olarak adlandırılan ve büyük oranda hastalığa neden olan bakteri grubu, tedavisi de zor hastalıkların nedeni oluyor. Bu grupta yer alan bakteriler bağırsaklarda, ciğerlerde, böbreklerde ve kanda enfeksiyonlara neden oluyorlar. Gram-negatif bakteriler, zaman içerisinde geliştirdikleri direnç ile birlikte de tehlike çanları çalmasına neden oluyor.
Canlı kemirgenlerde yapılan çalışmalarda Iolamicin, akut kansızlığı ve kan enfeksiyonlarını tedavi etmeyi başardı. Bağırsak mikrobiyomuna ise hiçbir zararı dokunmadı.
Araştırmacılar şimdi bu antibiyotikleri daha da geliştirmek ve insanlı testlerde kullanmak için çalışmalarını sürdürmeyi planlıyor. Böylelikle dünya çapında milyonlarca kişiye ihtiyaçları olan tedavi sağlanabilecek. Her yıl binlerce kişi bu bakterilerin neden olduğu hastalıklara bağlı olarak hayatını kaybediyor.
Araştırma Nature'da yayımlandı.
![Doom, Şimdi de Bağırsak Bakterilerinde Çalıştırıldı [Video]](https://imgrosetta.webtekno.com/file/526139/640xauto.jpg)
